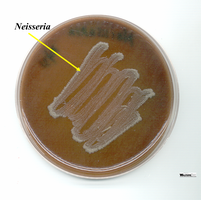
Neisseria colonies on chocolate agar
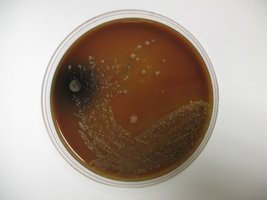
Neisseria on chocolate agar with oxidase test

BackNeisseria and Clostridium: Clinical Identification and Laboratory Techniques
Study Guide - Smart Notes
Tailored notes based on your materials, expanded with key definitions, examples, and context.
Neisseria
General Characteristics
Neisseria is a genus of gram-negative cocci that typically occur in pairs (diplococci) with flattened adjacent sides. Two primary human pathogens in this genus are Neisseria gonorrhoeae and Neisseria meningitidis. These bacteria are fastidious, requiring enriched media and increased CO2 for laboratory growth.
Pathogenic species: N. gonorrhoeae (causes gonorrhea), N. meningitidis (causes meningitis)
Virulence factors: Pili, adhesins, endotoxins, resistance to phagocytosis (capsule in N. meningitidis)
Nonpathogenic species: N. sicca, N. subflava, N. flavescens, N. mucosa (commonly found in the respiratory tract)

Laboratory Identification of Neisseria
Neisseria species are isolated from clinical specimens using specialized media and atmospheric conditions. The following steps outline the identification process:
Sample collection: Throat swab from patient
Primary isolation medium: Chocolate agar (enriched with lysed red blood cells, brown appearance)
Incubation: Plates are incubated in a candle jar to provide increased CO2
Chocolate Agar
Chocolate agar is an enriched medium used for the growth of fastidious organisms like Neisseria. It is prepared by heating a rich medium (e.g., Tryptic Soy Agar) and adding defibrinated sheep red blood cells at 80°C, causing cell lysis and release of hemoglobin, which gives the medium its characteristic brown color.
Purpose: Supports growth of Neisseria and other fastidious bacteria
Appearance: Brown, opaque medium
Oxidase Test
The oxidase test is a key biochemical test for the presumptive identification of Neisseria. Neisseria species produce the enzyme cytochrome oxidase, which catalyzes the transfer of electrons to oxygen.
Test principle: Addition of oxidase reagent (tetramethyl-p-phenylenediamine HCl) to a colony results in a color change (pink → maroon → blue-black) if cytochrome oxidase is present.
Interpretation: Positive test = purple/blue-black color; Negative test = no color change
Summary Table: Key Laboratory Features of Neisseria
Feature | Description |
|---|---|
Gram Stain | Gram-negative diplococci |
Growth Requirements | Chocolate agar, increased CO2 |
Oxidase Test | Positive (blue-black color) |
Colony Morphology | Small, raised, grayish-white colonies |
Clostridium
General Characteristics
Clostridium is a genus of gram-positive bacilli (rods) that are obligate anaerobes and endospore formers. Most species produce potent toxins, some of which are medically significant.
Key species: C. botulinum (botulism), C. perfringens (gas gangrene, food poisoning), C. difficile (pseudomembranous colitis)
Pathogenesis: Toxin production, spore formation, anaerobic metabolism

Clostridium botulinum and Botulism
Botulism is a neuroparalytic disease caused by ingestion of Clostridium botulinum toxin. In infants, it is often associated with ingestion of spores (e.g., from honey), which germinate and produce toxin in the gut, leading to "floppy baby syndrome" (flaccid paralysis).
Mechanism: Neurotoxin binds to acetylcholine receptors, blocking neurotransmission and causing paralysis
Clinical relevance: Dangerous in infants due to immature gut flora
Laboratory Identification of Clostridium
Clostridium species are identified using selective and differential media under anaerobic conditions. Key laboratory techniques include:
SPS (Sulfite Polymyxin Sulfadiazine) Agar: Selective for Clostridium, differential for H2S production (black colonies indicate H2S)
Blood Agar: Used to observe hemolysis patterns (double zone: inner beta, outer alpha hemolysis)
Thioglycollate Medium: Supports anaerobic growth; contains reducing agents and an oxygen indicator (methylene blue or resazurin)
Brewer's Anaerobic Jar: Sealed jar with GasPak to remove O2; indicator turns white in anaerobic conditions

Thioglycollate Broth: Oxygen Requirements
Thioglycollate broth is used to determine the oxygen requirements of bacteria:
Obligate anaerobes: Grow only at the bottom (anaerobic zone)
Obligate aerobes: Grow only at the top (oxygen-rich zone)
Facultative anaerobes: Grow throughout the medium
Microaerophiles: Grow just below the surface

Summary Table: Key Laboratory Features of Clostridium
Feature | Description |
|---|---|
Gram Stain | Gram-positive rods |
Oxygen Requirement | Obligate anaerobe |
Spore Formation | Yes |
SPS Agar | Black colonies (H2S production) |
Blood Agar | Double zone hemolysis |
Clinical Applications and Safety
Infant botulism: Avoid feeding honey to infants under 1 year due to risk of C. botulinum spores
Hospital infection control: C. difficile can cause outbreaks in patients on antibiotics
Additional info: The laboratory identification of Neisseria and Clostridium is essential for diagnosis and treatment of diseases such as gonorrhea, meningitis, botulism, and pseudomembranous colitis. Proper use of selective media, atmospheric conditions, and biochemical tests ensures accurate identification in clinical microbiology.